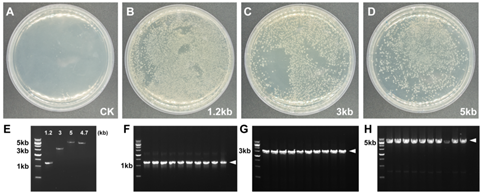
产品细节图片7

一步法快速克隆试剂盒(Hieff Clone Plus On
e Step Cloning Kit)研选同类产品更多 >
万千商家帮你免费找货
0 人在求购买到急需产品
- 详细信息
- 用户评价
- 文献和实验
- 技术资料
- 保存条件:
-20℃
- 保质期:
有效期1年
- 英文名:
Hieff Clone Plus One Step Cloning Kit
- 库存:
大量
- 供应商:
翌圣生物科技(上海)股份有限公司
- 规格:
50T
Hieff Clone® Plus One Step Cloning Kit是一款简便、快速、高效的DNA定向克隆产品,该试剂盒可以将PCR产物定向克隆至任何载体的任何位点,可高效克隆50 bp-10 kb片段。将载体线性化,并在插入片段正、反向PCR引物5’端引入15-25 bp的线性化载体末端同源序列,使得插入片段PCR产物5’和3’末端分别带有与线性化载体两末端对应的完全一致的序列。PCR产物和线性化载体在重组酶的作用下,仅需50℃反应20 min即可进行转化,完成定向克隆。克隆阳性率可达95%以上
产品组分
| 组分编号 | 组分名称 | 产品规格 | |
| 10911ES20 (20 T) | 10911ES50(50 T) | ||
| 10911-A | 2×Hieff Clone® Enzyme Premix | 200 μL | 500 μL |
| 10911-B | 500 bp Control Insert (25 ng/μL) | 5 μL | 5 μL |
| 10911-C | pUC 19 Control Vector, linearized (50 ng/μL) | 5 μL | 5 μL |
产品应用
快速克隆;定向克隆;定点突变。运输与保存方式
冰袋运输。-20℃保存,有效期1年。注意事项
1. 需自备的材料:
1)自备样品:自备好线性化载体和插入片段。
2)自备试剂(仅罗列部分):
① 超级感受态:转化效率>108 cfu/μg,如翌圣DH5α超级感受态细胞(Cat#11802);
② 高保真酶: 2×Hieff Canace® Gold PCR Master Mix(Cat#10149)或其他等效产品;
③ 菌落PCR mix:2×Hieff® Robust PCR Master Mix(With Dye)(Cat#10106)或其他等效产品;
④ 核酸染料:YeaRed Nucleic Acid Gel Stain (10,000 × in Water)(Cat#10202)或其他等效产品;
3)自备仪器耗材(仅罗列部分):PCR仪,水平电泳槽,切胶仪,EP管等;
2. 为了您的安全和健康,请穿实验服并佩戴一次性手套操作。
3. 本产品仅作科研用途!
实验流程

一. 制备线性化载体
选择合适的克隆位点,并对载体进行线性化。建议尽量选择无重复序列且GC含量均匀的区域进行克隆。载体克隆位点上下游25 bp区域内GC含量均在40%-60%范围内最佳。线性化载体可通过限制性内切酶酶切或反向PCR扩增获得。
1.酶切制备线性化载体
1)双酶切线性化:线性化完全,转化背景低。建议使用。
2)单酶切线性化:线性化程度较差。可适当延长酶切时间以降低转化背景。
【注】:不含插入片段的假阳性克隆是由未线性化环状载体转化而形成的。若这种假阳性克隆比例较高,建议重新制备线性化载体。
2.反向PCR扩增制备线性化载体
建议使用高保真聚合酶(如:Hieff CanaceTM High-Fidelity DNA Polymerase,Cat No. 10135ES)进行载体扩增,以减少扩增突变的引入。PCR扩增模板应尽量使用预线性化质粒,以防止残留环状质粒模板对克隆阳性率的影响。
Hieff CloneTM重组反应体系兼容几乎所有酶切反应体系和常规PCR反应体系,当载体酶切产物或反向PCR扩增产物纯度较高时,可以无需纯化,直接进行重组反应。但纯度较低且有可能含有未线性化环状质粒时,建议使用高质量的试剂盒对线性化载体进行胶回收纯化,以提高产物纯度并去除一部分未线性化的环状载体,有利于提高重组效率。
二. PCR扩增制备插入片段
1.设计扩增引物
Hieff CloneTM引物设计方式:通过在插入片段正、反向PCR引物的5’端引入15-25 bp(不包括酶切位点)的线性化载体末端同源序列,使得插入片段PCR产物5’和3’末端分别带有与线性化载体两末端对应的完全一致的序列。
插入片段正向扩增引物设计方式:
5’—上游载体末端同源序列+酶切位点(可保留或删除)+基因特异性正向扩增引物序列—3’
插入片段反向扩增引物设计方式:
3’—基因特异性反向扩增引物序列+酶切位点(可保留或删除)+下游载体末端同源序列—5’
【注】:①基因特异性正/反向扩增序列即常规插入片段正/反向扩增引物序列;
②上游/下游载体末端同源序列为线性化载体最末端序列(用于同源重组),GC含量40%-60%为佳。
推荐使用翊圣无缝克隆引物设计软件(http://122.112.245.84:8080/hieff-clone/),自动生成插入片段的扩增引物。若手动设计,可参照以下实例

|
1)如载体选用双酶切线性化(Hind III + EcoR I): |
|
|
|
2) 如克隆载体选用单酶切线性化(BamH I):
(注:克隆完成后插入片段两端都具有完整的BamH I酶切位点)
|
|
3)如载体选用反向PCR扩增制备:
(注:克隆完成后插入片段将与载体无缝拼接) |
图2 插入片段引物设计方案
【注】:最终引物长度超过40 bp,建议选用PAGE纯化方式进行引物合成。计算扩增引物退火温度时,只需计算基因特异性扩增序列的Tm值,载体末端同源序列不应参与计算,为了得到高效率克隆,建议Tm≥48℃。
2.插入片段PCR扩增
插入片段扩增可用任意PCR酶扩增,无需考虑产物末端有无A尾 (重组过程中将被去除,在最终载体中不会出现)。但为了减少扩增突变的引入,建议使用高保真聚合酶进行扩增(Hieff CanaceTM High-Fidelity DNA Polymerase,Cat No. 10135ES)。
PCR扩增结束后,取少量产物进行琼脂糖凝胶电泳以检验扩增产量和特异性。Hieff CloneTM重组反应体系兼容常规PCR反应体系。因此,如果扩增模板不是与载体抗性相同的环状质粒,且PCR产物电泳条带单一,则扩增产物可以无需纯化,直接用于重组反应。但PCR扩增产物纯度较低时,建议使用高质量的试剂盒对PCR扩增产物进行胶回收纯化,以提高产物纯度,有利于提高重组效率。
三. 线性化载体与插入片段浓度测定
推荐使用琼脂糖凝胶电泳比较条带亮度的方法对DNA进行定量。将线性化载体和插入片段扩增产物做数个等体积稀释梯度,原始产物和稀释后产物各取1 μL进行琼脂糖凝胶电泳,与DNA分子量标准(DNA Marker)比较条带亮度以确定其近似浓度。
四. 重组反应
1. 线性化载体与插入片段使用量计算
Hieff CloneTM重组反应体系最适载体使用量为0.03 pmol;最适载体与插入片段摩尔比为1:2-1:3,即最适插入片段使用量为0.06-0.09 pmol。这些摩尔数对应的DNA质量可由以下公式粗略计算获得:
最适载体使用量 = [0.02×载体碱基对数]ng (0.03 pmol)
最适插入片段使用量 = [0.04×插入片段碱基对数]ng (0.06 pmol) 或= [0.06×插入片段碱基对数]ng (0.09 pmol)
例如,将长度为2 kb的插入片段克隆至长度为5 kb的载体时,载体的最适使用量应为:0.02 × 5000 = 100 ng;插入片段最适使用量应为:0.04 × 2000 = 80 ng或0.06 × 2000=120 ng。
【注】: 1)当插入片段长度大于载体时,最适载体与插入片段使用量的计算方式应互换,即插入片段当做载体,载体当做插入片段进行计算。
2)线性化载体的使用量应在50-200 ng之间;插入片段扩增产物的使用量应在20-200 ng之间。当使用上述公式计算最适使用量超出这个范围时,则选择最低或最高使用量即可。
3)线性化载体和插入片段扩增产物未纯化,直接使用时,使用总体积应不超过反应体系体积的1/5,如20 μL体系不超过4 μL。
2.反应体系(推荐冰上配制,各组分使用前需混匀)
|
组分 |
重组反应 |
阴性对照-1 |
阴性对照-2 |
阳性对照 |
|
ddH2O |
Up to 20 μL |
Up to 20 μL |
Up to 20 μL |
Up to 20 μL |
|
2×Hieff Clone Enzyme Premix |
10 μL |
0 μL |
0 μL |
10 μL |
|
线性化载体 |
X μL |
X μL |
0 μL |
1 μL |
|
插入片段 |
Y μL |
0 μL |
Y μL |
1 μL |
【注】:1)X和Y分别是根据公式计算得到线性化载体和插入片段用量。
2)阴性对照-1可用来确认线性化载体有无环状质粒残留,可选择性进行。
3)当插入片段扩增模板是与载体抗性相同的环状质粒时,可用阴性对照-2来确认有无环状质粒模板残留,可选择性进行。
4)试剂盒中提供阳性对照反应所需组分,可用来排除其他实验材料及操作因素的影响,可选择性进行。
3.重组反应
1)体系配制完成后,用移液器轻轻吸打混匀各组分,短暂离心将反应液收集至管底。
2)置于50℃反应20 min。当插入片段>5 kb时,可将孵育温度延长至25 min。
【注】:建议在PCR仪或水浴锅等温控精确的仪器上进行反应。
3)待反应完成后,建议将反应管置于冰上冷却5 min,以防温度过高降低感受态转化效率。
4)反应产物可直接进行转化,也可储存于-20℃,待需要时解冻转化。
五. 重组产物转化、涂板
1)在冰上解冻克隆感受态细胞(如:DH5α Chemically Competent Cell,Cat No. 11802ES)。
2)取10 μL冷却重组产物,加入到100 μL感受态细胞中,轻弹管壁数下混匀,在冰上放置30 min。
3)42℃热激90秒,冰浴孵育2 min。
4)加入900 μL SOC或LB培养基,37℃孵育10 min充分复苏。37℃,200 rpm,摇菌45 min。
5)5000 rpm离心3 min,弃掉900 μL上清。用剩余培养基将菌体重悬,用无菌涂布棒在含有正确抗性的平板上轻轻涂匀。待菌液被吸收,将平板倒置,于37℃过夜培养。
六. 克隆鉴定
最方便快捷的方法是菌落PCR。用无菌的枪头或牙签将单个菌落挑至20-50 μL LB培养基中混匀,直接取1 μL作为PCR模板。推荐至少用一条通用测序引物进行菌落PCR,这样可以避免PCR假阳性的产生。后续也可做酶切或测序鉴定。
应用实例
图3:Hieff CloneTM Plus One Step Cloning Kit可以有效克隆不同长度的单片段基因。
A-D:重组转化平板。E:插入片段和载体浓度检测电泳图。F-H:插入片段PCR鉴定电泳图。箭头指示目的条带。载体:pFastBac1,4.7 kb,插入片段大小分别是1.2 kb,3 kb和5 kb,载体与插入片段摩尔比:1:3,重组反应条件:50℃,20 min。
常见问答
1、最佳克隆位点选择?
答:在选择克隆位点时,应避免选择克隆位点上下游50 bp内有重复序列的区域。当克隆位点上下游25 bp区域内GC含量均在40%-60%范围内时,重组效率将达到最大。若高于70%或者低于30%,重组效率会受到较大影响。
2、无克隆长出或克隆数较少?
答:出现该情况,建议同时使用试剂盒所附带的阳性对照,可排除试剂盒本身的影响,并进行进一步判定,主要有以下可能情况:
1)引物设计不合适:推荐【同源序列(15-25 bp)+完整的酶切位点+基因特异性扩增引物】,GC含量40% - 60%。
2)感受态细胞效率低:使用新鲜制备或妥善冻存的感受态细胞,确保其转化效率>107 cfu/μg。每次操作时可设置一组转化质粒的对照实验,以检测感受态细胞的转化效率。选择克隆感受态细胞(如DH5α),不能选择表达感受态细胞。
3)线性化载体和插入片段扩增产物的使用量不足/过量,或者比例不佳:尽量按照推荐的量和比例配制重组反应体系。
4)线性化载体和插入片段扩增产物不纯,抑制反应:线性化载体和插入片段扩增产物未纯化,直接使用时,使用总体积应不超过反应体系体积的1/5,如20 μL体系不超过4 μL。建议线性化载体、插入片段扩增产物进行凝胶回收纯化,纯化产物溶解在ddH2O中。
3、 出现较多假阳性
答:主要有以下可能情况:
1)载体线性化不完全:即使是痕量未完全酶切的载体也会产生很高的转化背景。可通过阴性对照检测载体是否线性化完全,优化酶切体系,提高限制性内切酶使用量、延长酶切反应时间、胶回收纯化酶切产物等都可以有效减少环状质粒残留。
2)插入片段扩增产物混有非特异扩增产物:建议:①优化PCR体系,提高特异性;②胶回收PCR产物;③鉴定更多克隆。
3)反应体系中混入了相同抗性的质粒:PCR扩增模板(载体或插入片段)为环状质粒时,若扩增产物直接用于重组反应,残留环状质粒模板会产生较高的转化背景。建议使用预线性化质粒作为扩增模板、扩增产物进行DpnI消化或扩增产物进行胶回收纯化。
4、菌落PCR无条带
答:主要有以下可能情况:
1)引物不正确:推荐使用载体的通用引物或至少使用一条通用引物进行菌落PCR检测。
2)PCR体系或程序不合适:没有目的条带也没有空质粒条带,建议优化PCR体系、程序;或者提取质粒,以质粒做模板PCR验证;或者进行酶切验证。
3)重组失败:没有目的条带,只有空质粒的条带,说明重组不成功,载体线性化不完全,建议优化酶切体系。
相关产品
| 产品名称 | 货号 | 规格 | 价格(元) | 促销价(元) |
| Top10化学感受态细胞HOT | 11801ES80 | 10×100 μL | 166.00 | - |
| Top10化学感受态细胞HOT | 11801ES92 | 100×100 μL | 1236.00 | - |
| DH5α化学感受态细胞HOT | 11802ES80 | 10×100 μL | 166.00 | - |
| DH5α化学感受态细胞HOT | 11802ES92 | 100×100 μL | 1236.00 | - |
| Hieff Canace® Gold 高保真DNA聚合酶HOT | 10148ES60 | 100 U | 683.00 | - |
| Hieff Canace® Gold 高保真DNA聚合酶HOT | 10148ES76 | 500 U | 2383.00 | - |
| Hieff Canace® Gold 高保真DNA聚合酶HOT | 10148ES80 | 1000 U | 4583.00 | - |
| 2×Hieff Canace® Gold 高保真酶预混液HOT | 10149ES03 | 1 mL | 553.00 | - |
| 2×Hieff Canace® Gold 高保真酶预混液HOT | 10149ES08 | 5 mL | 1453.00 | - |
| Hieff Clone® 多片段一步法快速克隆试剂盒HOT | 10912ES10 | 10 T | 457.00 | 410.00 |
| Hieff MutTM 定点突变试剂盒 | 11003ES10 | 10 T | 720.00 | |
| Hieff MutTM多点突变试剂盒 | 11004ES10 | 10 T | 1228.00 |
HB200219
风险提示:丁香通仅作为第三方平台,为商家信息发布提供平台空间。用户咨询产品时请注意保护个人信息及财产安全,合理判断,谨慎选购商品,商家和用户对交易行为负责。对于医疗器械类产品,请先查证核实企业经营资质和医疗器械产品注册证情况。
用户评价
暂无用户评价
文献和实验[1]. Jiang, Y., et al., Plants transfer lipids to sustain colonization by mutualistic mycorrhizal and parasitic fungi[J]. Science, 2017.(中科院植物生理生态研究所,王二涛组,IF37.205)
[2]. Xing, Y.H., et al., SLERT Regulates DDX21 Rings Associated with Pol I Transcription[J]. Cell, 2017. 169(4): p. 664-678.e16.(中科院生物化学与细胞生物学研究所,陈玲玲组,IF30.41)
[3]. Zhu T, Zhao Y, Wu Y, et al. The Staphylococcus epidermidis gdpS regulates biofilm formation independently of its protein-coding function[J]. Microb Pathog, 2017,105: 264–271.(IF2.0)
[4]. Li N, Hong T, Li R, et al. Cherry Valley Ducks Mitochondrial Antiviral-Signaling Protein-Mediated Signaling Pathway and Antiviral Activity Research[J]. Front Immunol, 2016,7:377.(IF6.4)
[5].Ma, Y., et al., miR-1908 Overexpression Inhibits Proliferation, Changing Akt Activity and p53 Expression in Hypoxic NSCLC Cells[J]. Oncol Res, 2016. 24(1): p. 9-15.(IF1.74)
[6].Yan, X., et al., The New Synthetic H2S-Releasing SDSS Protects MC3T3-E1 Osteoblasts against H2O2-Induced Apoptosis by Suppressing Oxidative Stress, Inhibiting MAPKs, and Activating the PI3K/Akt Pathway[J]. Front Pharmacol, 2017. 8: p. 07.(IF4.4)
[7].Lu, J., et al., Tiron Inhibits UVB-Induced AP-1 Binding Sites Transcriptional Activation on MMP-1 and MMP-3 Promoters by MAPK Signaling Pathway in Human Dermal Fibroblasts[J]. PLoS One, 2016. 11(8): p. e0159998.(IF2.8)
[8].Wu, R., et al., Direct regulation of the natural competence regulator gene tfoX by cyclic AMP (cAMP) and cAMP receptor protein (CRP) in Vibrios[J]. Sci Rep, 2015. 5: p. 14921.(IF4.25)
[9].He, D.X., et al., A methylation-based regulatory network for microRNA 320a in chemoresistant breast cancer[J]. Mol Pharmacol, 2014. 86(5): p. 536-47.(IF3.92)
[10].Liang, W., et al., Anti-Restriction Protein, KlcAHS, Promotes Dissemination of Carbapenem Resistance[J]. Front Cell Infect Microbiol, 2017. 7: p. 150.(IF4.3)
[11].Wang, X., et al., Improved PKS gene expression with strong endogenous promoter resulted in geldanamycin yield increase[J]. Biotechnol J, 2017.(IF2.599)
[12]. Li X, Liu C X, Xue W, et al. Coordinated circRNA biogenesis and function with NF90/NF110 in viral infection[J]. Molecular Cell, 2017. (IF 14.7)
[13].Du L, Dong S, Zhang X, et al. Selective oxidation of aliphatic C–H bonds in alkylphenols by a chemomimetic biocatalytic system[J]. Proceedings of the National Academy of Sciences, 2017: 201702317.(IF9.661)
, a two-step cloning strategy is described following the modular exchange principle as a general guideline for converting antibodies into an scFv format suitable for periplasmatic expression in E. coli .
Nature of the InsertThe cloning of PCR-amplified fragments into a linear vector is typically a rapid and efficient process. However, not all PCR fragments will clone with the same efficiency into the same vector. These differences
♦ 适用范围:适用于快速提取植物组织细胞总RNA本试剂盒在室温储存12个月不影响使用效果。♦ 储存事项:1. 所有的溶液应该是澄清的,如果环境温度低时溶液可能形成沉淀,此时不应该直接使用,可在37℃水浴加热几分钟,即可恢复澄清。2. 不合适的储存于低温(4℃或者-20℃)会造成溶液沉淀,影响使用效果,因此运输和储存均在室温下(15℃-25℃)进行。3. 避免试剂长时间暴露于空气中产生挥发、氧化、PH值变化,各溶液使用后应及时盖紧盖子。♦ 产品介绍:独特的裂解液/β-巯基乙醇迅速裂解细胞和灭












